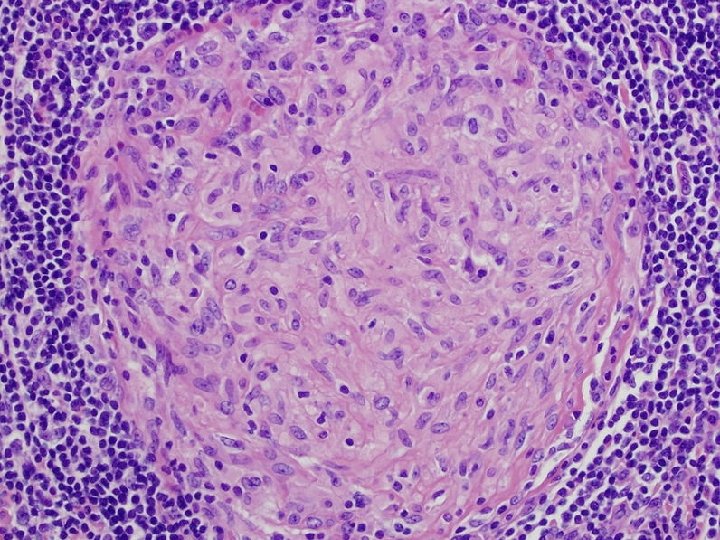

T CELL MEDIATED IMMUNITY Cell Mediated Immunity CELL






































































- Slides: 70

T CELL MEDIATED IMMUNITY (Cell Mediated Immunity)

CELL MEDIATED IMMUNITY (CMI) * Adaptive immune response based on antigen specific T cells * Antigen specific T cells * CD 8 (cytotoxic) * CD 4 (helper) * TH 1 * TH 2 * Transfer to naïve recipient (operational definition) * Not with antiserum * Can with lymphoid cells (syngeneic donor and recipient) * Mature naïve T cells must be activated by specific antigen in secondary lymphoid tissues

ACTIVATION OF NAÏVE T CELLS INTO EFFECTOR T CELLS * Purpose of secondary lymphoid tissues * Sites for initiation of adaptive response * Examples * * Skin and soft tissues (SST) to regional lymph nodes Blood stream to spleen Respiratory mucosa to BALT and tonsils Gastrointestinal mucosa to Peyer’s patches (GALT) * Dendritic cells important in SST infections * Immature * Phagocytic and migratory from infection sites * Mature * Interaction with T cells in 2 nd lymphoid tissues



ACTIVATION OF NAÏVE T CELLS INTO EFFECTOR T CELLS * Enter T cell zone of 2 nd lymphoid tissue and encounter * Dendritic cells * Macrophages * Presentation of antigen * Activation into effector T cells * Effector cells * Remain in 2 nd lymphoid tissue (CD 4 TH 2) * Travel to infection site (CD 8 and CD 4 TH 1) * No encounter with specific antigen * Re-circulation to bloodstream



HOMING OF T LYMPHOCYTES * Homing * Movement of naïve T cells into secondary lymphoid tissue or effector T cells to infection site * Homing determined by * Chemokines * CCL 19 and CCL 21 * Cell adhesion molecules (CAM’s)

MOVEMENT OF T CELLS BY INTERACTION OF CAM’S * Interaction (contact) is mediated by * Cell adhesion molecules (CAM’s) * * On surface of leukocytes and target cells Work independently of antigen Direct specific cell to cell contact Classification based on * Structure * CD nomenclature

CLASSIFICATION OF CAM’S ON STRUCTURAL BASIS * Selectins * Surface of leukocytes and macrophages * L selectin * Initiates interaction with endothelial cells * Vascular addressins * Surface of endothelial cells * Gly. CAM-1 and CD 34 * Initiates interaction with leukocyte and macrophage selectins


CLASSIFICATION OF CAM’S ON STRUCTURAL BASIS * Integrins * Glycoproteins on surface of leukocytes and dendritic cells * Lymphocyte function associated antigen (LFA-1) * Initiates strong binding to * Immunoglobulin superfamily molecules * Intercellular adhesion molecules (ICAM’s) * Strong binding allows T cells to squeeze between endothelial cells

CLASSIFICATION OF CAM’S ON STRUCTURAL BASIS * Immunoglobulin superfamily molecules * Located on leukocytes, APC’s and endothelial cells * CD 2, ICAM-1, ICAM -2 * Initiates interaction with integrins * Various roles in cell adhesion * Passage of T cells between endothelial cells * LFA-1 to ICAM’s * Interaction of T cells with APC’s * CD 2 to LFA-3





ACTIVATION OF NAÏVE T CELLS REQUIRES CO-STIMULATION * Antigen presenting cells (APC’s) deliver both * Antigenic specific stimulation * Co-stimulation from professional APC’s * Dendritic cells, macrophages, B lymphocytes * Co-stimulatory molecule is B 7 * B 7 on APC’s binds to CD 28 on T cells


CHARACTERISTICS OF PROFESSIONAL ANTIGEN PRESENTING CELLS * Mechanism of antigen uptake * Expression of MHC molecules * Expression of B 7 * Antigens presented * Location in secondary lymphoid tissues * Location in body


PHAGOCYTOSIS INDUCES COSTIMULATORY ACTIVITY IN MACROPHAGES * Resting macrophages express * No B 7 * Low level MHC II * Degradation of bacteria in phagolysosome release molecules which stimulate expression of B 7 and MHC II * Lipopolysaccharide * Macrophages most commonly present antigens to CD 4 T cells * Listeria monocytogenes avoids MHC II presentation


PHAGOCYTOSIS INDUCES MATURATION OF DENDRITIC CELLS * Immature dendritic cells present in skin and soft tissues * High level of phagocytosis and no co-stimulatory activity * Phagocytosis induces * Migration to lymphoid tissue * Maturation to mature dendritic cells * Interdigitating reticular cells * Expression of * B 7, MHC II, CCL 18 and DC-SIGN * Dendritic cells stimulate CD 4 and CD 8 T cell responses



ENDOCYTOSIS INDUCES B 7 EXPRESSION IN B CELLS * Immunoglobulin receptors on B cells selective bind soluble protein antigen from extracellular environment * Lipopolysaccharide * Antigen / Immunoglobulin complex is internalized by * Receptor mediated endocytosis * Complexes delivered to endocytic vesicles * Degraded into peptides and bound to MHC II * Expression of B 7 * B cells present antigen to CD 4 T cells



ANTIGEN ACTIVATION OF T CELL RECEPTOR COMPLEX INITIATES INTRACELLULAR SIGNALING PATHWAYS * Antigen binding transmits signal via CD 3 and zeta proteins * Transmitted signal activates * Receptor associated kinases (Fyn) * Fyn leads to phosphorylation of ITAM’s * Immunoreceptor tyrosine based activation motifs (ITAM’s) * Cytoplasmic tails of CD 3 and zeta proteins

ANTIGEN ACTIVATION OF T CELL RECEPTOR COMPLEX INITIATES INTRACELLULAR SIGNALING PATHWAYS * ZAP-70 (cytoplasmic tyrosine kinase) binds to phosphorylated ITAM’s of zeta chain * Co-receptors (CD 4 and CD 8), with associated tyrosine kinase (Lck), bind to MHC molecules * Co-receptor binding to MHC allows Lck to phosphorylate and activate ZAP-70



PROLIFERATION AND DIFFERENTIATION OF ACTIVATED T CELLS BY INTERLEUKIN-2 * Naïve T cells express low affinity IL-2 receptor consisting of beta and gamma chains only * Activation of naïve T cells induces * Synthesis and secretion of IL-2 * Synthesis of IL-2 receptor alpha chain * Alpha chain combines with beta and gamma chains to make high affinity IL-2 receptor * IL-2 binds to receptor and initiates T cell proliferation


ANTIGEN RECOGNITION BY NAÏVE T CELLS IN ABSENCE OF COSTIMULATION * Naïve T cell only activated by professional APC carrying specific peptide: MHC complex and co-stimulatory molecule * T cell beomes anergic when it encounters APC carrying specific peptide: MHC complex without co-stimulatory molecule * No effect on T cell which encounters APC carrying no specific peptide: MHC complex but has co-stimulatory molecule


EFFECTOR OPTIONS OF CD 8 AND CD 4 T CELLS FOLLOWING ANTIGEN ACTIVATION * CD 8 committed to becoming cytotoxic effector cells * CD 4 T cells can differentiate along two pathways * TH 1 (help with CMI) * TH 2 (help with humoral immune response) * Mechanisms of differentiation not well understood * Most immune responses involve both TH 1 and TH 2


CD 4 T CELL RESPONSE TO MYCOBACTERIUM LEPRAE * Mycobacterium leprae is an intracellular pathogen, agent of leprosy and directs either TH 1 or TH 2 response * Most effective immune response is mediated by TH 1 cells * Immune response mediated by TH 1 cells results in * Tuberculoid leprosy * Immune response mediated by TH 2 cells results in * Lepromatous leprosy






Figure 6 -21


ACTIVATION OF NAÏVE CD 8 T CELLS TO CYTOTOXIC EFFECTOR CELLS * Activation of naïve CD 8 cells requires strong costimulation * Dendritic cells provide strong co-stimulation * Express high levels of B 7 * APC with sub-optimal co-stimulation require CD 4 T cell help * Naïve CD 8 and CD 4 cells must recognize specific antigen on on same APC

ACTIVATION OF NAÏVE CD 8 T CELLS TO CYTOTOXIC EFFECTOR CELLS * Mechanisms of CD 4 help * CD 4 effector T cells secrete cytokines stimulating APC to increase level of B 7 * Naïve CD 4 T cells secrete interleukin-2 which stimlates CD 8 cells * Requirement for stronger co-stimulation of CD 8 cells means activation only when evidence of infection certain


PERFORMANCE OF EFFECTOR T CELL FUNCTIONS * Classification of molecules which perform functions * Cytokines * Proteins made by cells and affect behavior of cells * Autocrine action * Paracrine action * Produced by all effector T cells * Cytotoxins * Proteins which kill target cells * Produced by cytotoxic CD 8 cells

CYTOTOXINS AND CYTOKINES OF T CELLS * T cells are distinguished by * Cytokines and cytotoxins produced and the effects on immune response * CD 4 T cells produce and act primarily through cytokines * Macrophage stimulating (TH 1) * B cell activating (TH 2) * CD 8 T cells produce and act primarily through cytotoxins * Perforin and Granzymes


SELECTIVE KILLING OF INFECTED CELLS BY CD 8 CYTOTOXIC T CELLS * Cytotoxic CD 8 kill by inducing apoptosis * Cells do not lyse or disintegrate but shrivel and shrink * Pathways of Apoptosis * Formation of transmembrane pores allowing proteolytic enzymes to enter * Perforin and granzymes cytotoxins * Induction of apoptosis signal following cell-cell binding * Fas ligand (CD 8 T cell) to Fas receptor (Target cell)


TH 1 T CELLS AND MACROPHAGE ACTIVATION * Macrophage activation * Enhancement of macrophage function against intracellular pathogens by TH 1 cells * Phagosome fused more efficiently with lysosome * Important with Mycobacteria * Activation of macrophages requires 2 signals provided by TH 1 cells * Interferon-gamma * CD 40 ligand


INTRACELLULAR PATHOGENS AND GRANULOMA FORMATION * Mycobacteria can resist killing by activated macrophages resulting in formation of granulomas * Granulomas * Localized inflammatory response characterized by * Central core of infected macrophages surrounded by activated T cell * Central core of granuloma * Macrophages fused into multinucleated giant cells surrounded by large single macrophages (epithelioid cells) * In tuberculosis, centers of large granulomas display cheeselike appearance * Caseation necrosis

TH 2 T CELLS AND ACTIVATION OF B LYMPHOCYTES * CD 4 TH 2 cells activate B cells which recognize same antigen * Cognate interaction * Activation takes place in secondary lymphoid tissue * Mechanism * TH 2 cell receptor binds to peptide: MHC II complex on B cell * TH 2 cell synthesizes * CD 40 ligand which binds to CD 40 receptor on B cell * Interleukin-4, interleukin-5, interleukin-6 * Stimulate proliferation and differentiation of B cells


KNOWLEDGE OF COGNATE INTERACTION IMPROVES VACCINE DESIGN AND EFFICACY * Vaccination of infants and young children against Haemophilus influenzae type b * Agent of invasive disease in children < 5 years * Meningitis and epiglottitis * Prior to vaccine availability * Morbidity of 1 in 200 children * Mortality of 5% * Approximately 70% of cases in children < 18 months * Major virulence factor is type b capsular polysaccharide


KNOWLEDGE OF COGNATE INTERACTION IMPROVES VACCINE DESIGN AND EFFICACY * 1980 vaccines consisted of * Purified type b capsular polysaccharide * Protects children > 18 months * 1990 vaccines consisted of * Purified type b capsular polysaccharide conjugated to protein * Act. HIB (Sanofi Pasteur) * Tetanus toxoid * Hib. TITER (Wyeth) * Diphtheria CRM 197 protein * Protects children > 2 months

